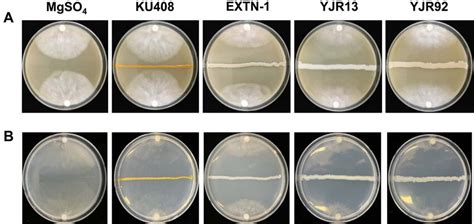

Pseudomonas Plecoglossicida: Key Characteristics
Pseudomonas plecoglossicida: Key Characteristics
Hey there, science enthusiasts and aquaculture aficionados! Today, we’re diving deep into the fascinating world of a particular microorganism: Pseudomonas plecoglossicida . This tiny bacterium, though often overlooked by the general public, plays a significant role in the health and sustainability of aquaculture, especially for certain fish species. Understanding the characteristics of *Pseudomonas plecoglossicida * isn’t just for microbiologists; it’s crucial for anyone involved in fish farming, research, or environmental science. We’re going to explore what makes this bacterium tick, from how it looks under a microscope to its genetic makeup and, most importantly, its impact as a pathogen. So, buckle up, because we’re about to uncover everything you need to know about this intriguing microbial entity, presented in a friendly, easy-to-digest way. Our goal here is to provide you with high-quality content that not only educates but also offers real value, helping you better grasp the complexities of bacterial life and its implications. Get ready to learn about Pseudomonas plecoglossicida and why its traits are so important to recognize.
Table of Contents
- Unveiling the Microscopic World: Morphological Characteristics
- Growth Habits: Cultural Characteristics in the Lab
- Unpacking Its Metabolism: Biochemical Characteristics
- Genetic Blueprint and Virulence: Genomic Insights
- Impact in the Water: Pathogenicity and Ecological Role
- Keeping It in Check: Identification and Control Strategies
- Wrapping It Up: Why These Characteristics Matter
Unveiling the Microscopic World: Morphological Characteristics
When we talk about the characteristics of *Pseudomonas plecoglossicida *, one of the first things scientists investigate is its morphology – essentially, what it looks like. Imagine peering through a powerful microscope; what would you see? Well, Pseudomonas plecoglossicida typically presents as a Gram-negative rod . This means it won’t retain the crystal violet stain during the Gram staining procedure, instead appearing pink or red under the microscope after counterstaining with safranin. This Gram-negative classification is really important because it tells us a lot about its cell wall structure, which, in turn, influences its resistance to certain antibiotics and disinfectants. Its rod shape is fairly common among bacteria, but it’s a distinct feature that helps differentiate it from spherical cocci or spiral-shaped spirilla. The size of these rods can vary slightly, but they are generally small, as you’d expect from a bacterium, often measuring around 0.5 to 1.0 micrometers in width and 1.5 to 3.0 micrometers in length. These guys are tiny , making up for their size with their impact! Another key morphological characteristic is their motility. Pseudomonas plecoglossicida is known to be motile , meaning it can move independently. This movement is usually facilitated by polar flagella , which are whip-like appendages that propel the bacterium through liquid environments. Think of them as tiny propellers allowing the bacteria to navigate their surroundings, which is incredibly useful for colonizing new areas or escaping unfavorable conditions within a host. The presence and arrangement of these flagella are often consistent across different strains, making it a reliable feature for identification. Understanding these morphological aspects is the foundational step in identifying and characterizing any new bacterial isolate, and for Pseudomonas plecoglossicida , these visual cues are critical initial indicators for microbiologists working in fish health and disease diagnostics. These seemingly simple traits are fundamental to its survival and ability to cause infections, making them a central part of its overall profile.
Growth Habits: Cultural Characteristics in the Lab
Beyond just how it looks, the characteristics of *Pseudomonas plecoglossicida * also include its cultural traits – essentially, how it behaves and grows in a controlled laboratory setting. This gives us invaluable clues about its nutritional requirements, environmental preferences, and typical colony appearance. When cultured on standard bacteriological media like Tryptic Soy Agar (TSA) or Brain Heart Infusion (BHI) agar, Pseudomonas plecoglossicida typically forms distinctive colonies. On TSA, you can expect to see round, smooth, glistening colonies that are usually off-white or yellowish in color. Sometimes, strains might exhibit a slight green or iridescent sheen, which is a common trait among some Pseudomonas species due to the production of soluble pigments. However, P. plecoglossicida is not typically known for producing the strong fluorescent pigments (like pyocyanin or pyoverdine) that are characteristic of other Pseudomonas species such as P. aeruginosa . This lack of strong pigmentation can sometimes be a distinguishing factor. Optimal growth generally occurs at mesophilic temperatures, meaning it thrives in moderate temperatures, typically between 25°C and 30°C . This temperature range is highly relevant to its pathogenic role, as it aligns well with the typical water temperatures found in aquaculture environments where fish like ayu (sweetfish) are farmed. Growth may be inhibited at higher temperatures, and it might grow more slowly at lower temperatures, but the ideal range is key to successful isolation and propagation in the lab. Furthermore, Pseudomonas plecoglossicida is an aerobic bacterium, which means it absolutely requires oxygen for growth. While some Pseudomonas species can grow anaerobically using nitrate as an electron acceptor, P. plecoglossicida primarily relies on aerobic respiration. This characteristic is often determined through biochemical tests, but it’s a critical piece of its cultural profile. The ability to grow rapidly and form visible colonies within 24-48 hours on appropriate media is also typical, allowing for relatively quick identification in a diagnostic laboratory. Observing these cultural characteristics helps researchers and diagnosticians isolate and identify the bacterium from infected fish samples, paving the way for targeted treatment and prevention strategies in aquaculture settings, underscoring the practical importance of these laboratory observations.
Unpacking Its Metabolism: Biochemical Characteristics
Delving deeper into the characteristics of *Pseudomonas plecoglossicida *, we uncover its biochemical profile – essentially, the metabolic activities and enzymatic reactions it performs. These biochemical traits are incredibly useful for precise identification and understanding how the bacterium interacts with its environment and host. One of the most common and important tests is the oxidase test . Pseudomonas plecoglossicida is oxidase-positive , meaning it possesses the cytochrome c oxidase enzyme. This enzyme is part of its electron transport chain and indicates that it uses oxygen as a terminal electron acceptor in aerobic respiration. This differentiates it from many other Gram-negative rods, which may be oxidase-negative. Another key characteristic is its catalase activity ; P. plecoglossicida is catalase-positive , producing the enzyme catalase which breaks down hydrogen peroxide into water and oxygen. This is a common defense mechanism against reactive oxygen species. When it comes to sugar fermentation, P. plecoglossicida is generally non-fermentative . Unlike many enteric bacteria that ferment sugars like glucose, Pseudomonas species typically metabolize sugars oxidatively rather than fermentatively. This means it breaks down sugars in the presence of oxygen, but it won’t produce acid and gas via fermentation pathways. This non-fermentative nature is a hallmark of the Pseudomonas genus and is a critical diagnostic indicator. Furthermore, it often tests positive for citrate utilization , meaning it can use citrate as its sole carbon source, and is negative for indole production , which helps distinguish it from other Gram-negative bacteria. Urease activity, which involves the breakdown of urea, is typically negative for P. plecoglossicida , further refining its biochemical fingerprint. Tests for motility, as mentioned in morphology, are also often confirmed biochemically, with positive results confirming its ability to move. Understanding these specific enzymatic reactions and metabolic pathways is vital for differentiating P. plecoglossicida from other bacterial species that might cause similar symptoms in fish. This biochemical fingerprint is like a unique metabolic ID card, helping microbiologists confirm its identity with a high degree of certainty, which is paramount for effective disease management in aquaculture.
Genetic Blueprint and Virulence: Genomic Insights
Now, let’s talk about the super cool characteristics of *Pseudomonas plecoglossicida * from a genomic perspective. Thanks to advanced sequencing technologies, we can look beyond the microscope and dive into the bacterium’s genetic blueprint – its DNA! The genome of Pseudomonas plecoglossicida holds all the instructions for its survival, reproduction, and, crucially, its ability to cause disease. Typically, Pseudomonas species, including P. plecoglossicida , have relatively large genomes, often ranging from 4 to 7 million base pairs, encoding thousands of genes. A significant part of genomic research focuses on identifying virulence factors . These are specific genes or gene products that contribute to the bacterium’s pathogenicity, essentially giving it the tools to infect and harm its host. For P. plecoglossicida , researchers have identified several potential virulence factors, including genes related to adhesion, toxin production, iron acquisition systems, and various secretion systems (like the Type III and Type VI secretion systems). Adhesion factors, such as fimbriae or pili, allow the bacteria to stick to host tissues, a critical first step in infection. Toxin production, although not as extensively characterized as in some other pathogens, likely plays a role in damaging host cells and tissues. Iron acquisition systems are vital because iron is an essential nutrient for bacterial growth, and pathogens often have sophisticated mechanisms (like siderophores) to snatch iron from their host. Furthermore, the presence of antibiotic resistance genes is a growing concern. Genomic studies can help track the evolution and spread of resistance in P. plecoglossicida , which is crucial for guiding effective treatment strategies in aquaculture. The ability to sequence and analyze the entire genome allows us to understand the evolutionary relationships of P. plecoglossicida with other Pseudomonas species and to identify unique genetic markers for rapid and accurate detection methods, such as PCR-based assays. This deep dive into its genetics provides an unprecedented level of detail about how this bacterium operates and what makes it a successful pathogen, offering vital clues for developing targeted prevention and control measures to protect fish populations.
Impact in the Water: Pathogenicity and Ecological Role
Moving on to a crucial aspect of the characteristics of *Pseudomonas plecoglossicida *: its role as a pathogen and its ecological niche. This bacterium is primarily recognized as a significant pathogen in aquaculture, particularly affecting fish species like the ayu (Plecoglossus altivelis) , also known as the sweetfish, which is where its species name originates. It causes a devastating disease known as pseudomoniasis or bacterial hemorrhagic septicemia, leading to substantial economic losses in the aquaculture industry. The disease manifests with various symptoms, including external hemorrhages, fin rot, skin ulcerations, and internal organ damage, such as splenomegaly (enlarged spleen) and necrosis in the liver and kidney. Infected fish often become lethargic, lose appetite, and may exhibit abnormal swimming patterns before succumbing to the infection. The mortality rates can be alarmingly high, especially in stressed or overcrowded conditions, which are unfortunately common in intensive farming operations. While ayu is its primary host, there’s evidence suggesting it might affect other freshwater fish species as well, making its impact potentially broader. The bacterium typically enters the fish through the gills or skin lesions, particularly when fish are stressed or injured, allowing it to quickly establish an infection. Once inside, its virulence factors come into play, enabling it to evade the host’s immune system and proliferate. From an ecological perspective, Pseudomonas plecoglossicida is found in aquatic environments, likely inhabiting the water, sediment, and possibly even the gut microbiota of healthy fish as a commensal or transient resident. However, under conditions that stress the fish, such as poor water quality, high stocking densities, or temperature fluctuations, it can shift from a benign presence to an opportunistic pathogen. Understanding these environmental triggers and the bacterium’s modus operandi is essential for developing robust biosecurity protocols and management strategies in fish farms. The economic impact of P. plecoglossicida outbreaks can be severe, leading to mass mortalities, reduced growth rates, and increased production costs due to treatment and prevention efforts. Thus, comprehending its pathogenic mechanisms and ecological behavior is not just academic; it’s a practical necessity for safeguarding fish health and ensuring the sustainability of aquaculture operations worldwide.
Keeping It in Check: Identification and Control Strategies
Finally, let’s talk about how we identify and control Pseudomonas plecoglossicida , which ties directly back to understanding its characteristics of *Pseudomonas plecoglossicida *. Accurate identification is the first step towards effective management. Traditional diagnostic methods involve isolating the bacterium from infected fish tissues (like kidney, spleen, or skin lesions) on selective or non-selective agar media, followed by Gram staining and a battery of biochemical tests, as we discussed earlier. The combination of its Gram-negative, rod-shaped, motile morphology, along with its cultural characteristics (mesophilic, aerobic growth, off-white/yellow colonies) and biochemical profile (oxidase-positive, catalase-positive, non-fermentative, etc.), forms a robust basis for identification. However, for quicker and more definitive results, molecular methods are increasingly used. Techniques like Polymerase Chain Reaction (PCR) , quantitative PCR (qPCR) , and 16S rRNA gene sequencing provide highly sensitive and specific ways to detect P. plecoglossicida by targeting unique genetic sequences. These molecular tools are invaluable for early detection, even before clinical signs become apparent, and for monitoring the bacterium’s presence in environmental samples or asymptomatic carriers. Once identified, controlling P. plecoglossicida in aquaculture relies on a multi-faceted approach. Antibiotics are often used for treatment during outbreaks, but this practice raises concerns about antibiotic resistance, making judicious use and susceptibility testing critical. Prevention is always better than cure, and key strategies include maintaining optimal water quality , ensuring proper stocking densities to reduce stress, implementing strict biosecurity measures to prevent pathogen introduction and spread (e.g., disinfecting equipment, controlling visitor access), and quarantining new fish before introducing them to existing populations. Vaccination is another promising avenue; developing effective vaccines against P. plecoglossicida could offer long-term protection for fish populations. Additionally, nutritional support to boost fish immunity and the use of probiotics to modify the gut microbiota are emerging as complementary strategies. By integrating these identification and control methods, based firmly on a thorough understanding of the bacterium’s characteristics, we can significantly mitigate the impact of P. plecoglossicida and promote healthier, more sustainable aquaculture practices. It’s all about being proactive and informed, guys!
Wrapping It Up: Why These Characteristics Matter
Alright, guys, we’ve covered a lot of ground today, exploring the many fascinating characteristics of *Pseudomonas plecoglossicida *. From its humble beginnings as a tiny, Gram-negative rod, we’ve journeyed through its growth habits, metabolic tricks, and even peered into its genetic makeup to understand what makes it tick. We’ve seen how its morphology, cultural preferences, biochemical reactions, and genomic features all contribute to its identity and, more importantly, its capability as a significant pathogen in aquaculture. We learned that this bacterium, while microscopic, wields considerable power, particularly over fish species like the ayu, causing diseases that can severely impact fish farming operations and livelihoods. Understanding these traits isn’t just about scientific curiosity; it’s about practical application. It helps researchers develop better diagnostic tools, allows fish farmers to implement more effective prevention strategies, and guides the development of new treatments, like vaccines, to protect our aquatic food sources. Every detail, from its preference for certain temperatures to the specific enzymes it produces, plays a crucial role in how we identify, manage, and ultimately combat this microbe. So, the next time you hear about Pseudomonas plecoglossicida , you’ll know it’s not just a complex name, but a complex organism with a story that has significant implications for global aquaculture. Keep learning, keep questioning, and remember that even the smallest organisms can hold the biggest lessons! Thank you for sticking around and learning with us.